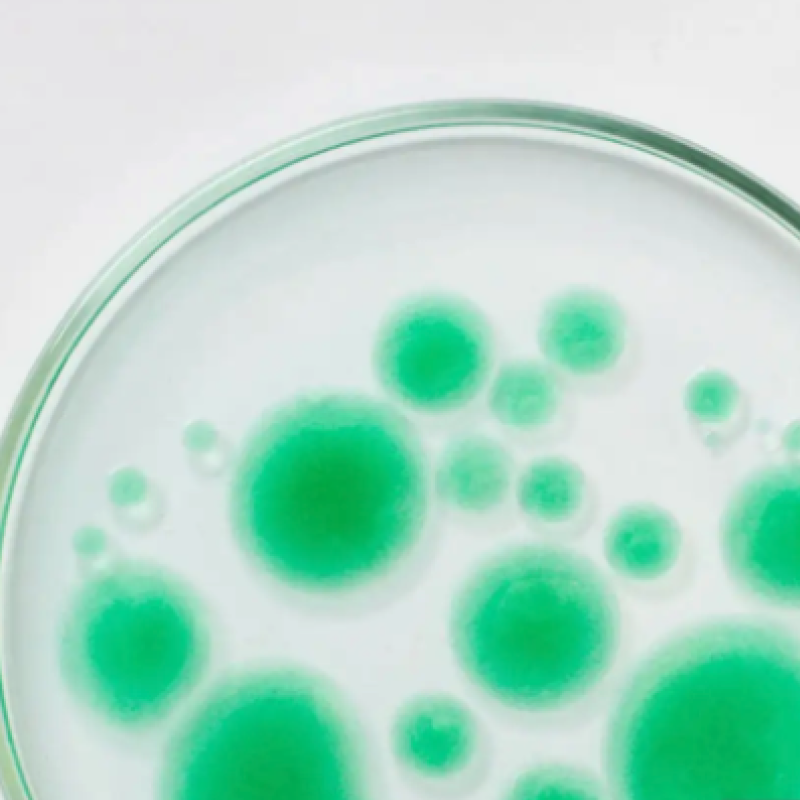

• Barátságos és közvetlen környezet
• Olcsó és hatékony kezelések a fogak egészségéért és a szép mosolyért
• Személyre szabott otthoni szájápolási protokoll elsajátítása
• Útmutatás és motiválás az egészségtudatos életre
A dentalhigiénikusi kezelés során plakkfestés, biofilm terápia, íny feletti és alatti fogkő eltávolítása történik.
Motiválunk a rendszeres otthoni fogápolásra, instruálunk a megfelelő eszközök használatára, eligazítunk a szájápolási eszközök útvesztőjében, segítünk a helyes étkezési szokások kialakításában.

Mikrobiológus szakember bevonásával kielemezzük a száj mikrobiomját. Savas irányú fogszuvasodás, lúgos hatású fogágybetegség irányában. Célunk az ideális mikrobiom kialakítása, alacsony csíraszámban.